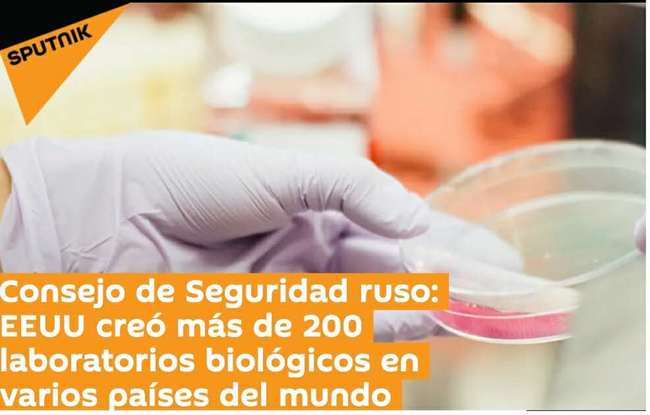

Komentarz: Amerykańskie laboratorium biologiczne w Kazachstanie może stać się regionalną „bombą wirusową”

Ostatnio w Kazachstanie odnotowano „niezidentyfikowane zapalenie płuc”, którego śmiertelność może być wyższa niż w przypadku koronawirusa. Z tego powodu opinia publiczna zwróciła uwagę na amerykańskie laboratorium biologiczne zlokalizowane w Kazachstanie.
Amerykańskie Laboratorium Biologiczne w Alma-Ata w Kazachstanie zostało założone w 2010 roku z kapitałem 60 milionów dolarów amerykańskich. W tym czasie Stany Zjednoczone ogłosiły, że zbudują tu największe laboratorium biologiczne w Azji Środkowej, mówiąc, że zadaniem laboratorium jest badanie niezwykle niebezpiecznych wirusów.
Strona internetowa Stanradar Kirgistanu opublikowała 11 lipca artykuł, w którym napisano, że Stany Zjednoczone są rzeczywistym właścicielem kazachskiego laboratorium biologicznego. Z jednej strony celem laboratorium biologicznego jest gromadzenie danych DNA miejscowej populacji, zwierząt i roślin, z drugiej zaś Laboratorium Biologiczne w Alma-Ata gromadzi również wiele groźnych patogenów - czytamy w tekście.
Według doniesień, Kazachstan jest naturalnym poligonem doświadczalnym dla eksperymentów wirusowych, który znajduje się bardzo blisko Rosji, Chin, Kirgistanu i Uzbekistanu. W subiektywnych okolicznościach lub przypadkowych wyciekach wirus może bardzo szybko rozprzestrzenić się na te kraje.